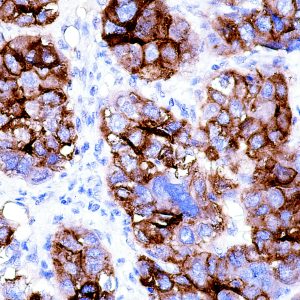
AM539

G
Showing 21–24 of 24 resultsSorted by latest
-
Anti-Glypican-3 (GPC3)
Price range: $350.00 through $1,149.00 Select options This product has multiple variants. The options may be chosen on the product page -

Anti-GLUT-1
Price range: $203.00 through $702.00 Select options This product has multiple variants. The options may be chosen on the product page -

Anti-Granulocyte
Price range: $223.00 through $905.00 Select options This product has multiple variants. The options may be chosen on the product page -

Anti-Glial Fibrillary Acidic Protein (GFAP)
Price range: $375.00 through $945.00 Select options This product has multiple variants. The options may be chosen on the product page

